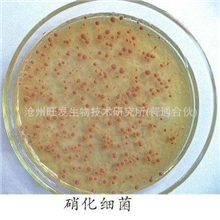
硝化细菌水族观赏鱼虾污水处理专用
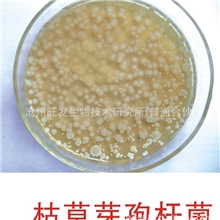
水产养殖水质调控污水处理枯草芽孢杆菌
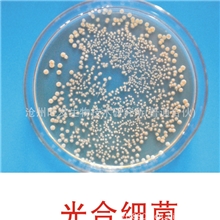
厂家直销水生动物苗种的开口饲料和饲料添加剂光合细菌
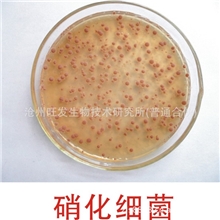
厂家直销用于水质调控底质改良污水处理的硝化细菌
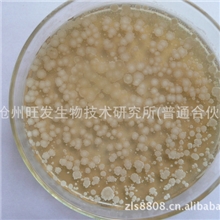
厂家供应生物有机肥发酵菌发酵粪便生活垃圾

沧州旺发生物技术研究所(普通合伙)
主营:枯草芽孢杆菌;纳豆芽孢杆菌;硝化细菌;地衣芽孢杆菌;植物乳杆菌;光合细菌;乳酸菌;肥水菌;底改活菌;EM菌种及培养基;等水产、畜禽养殖用微生态制剂单一菌粉;及复合菌粉及成品;益水素、亚硝净;特效水产酵母;破壁酵母;高活性饲料酵母;宠物风味酵母;发酵豆粕;生物有机肥发酵菌;等水产、畜禽用微生态制剂产品
主营:枯草芽孢杆菌;纳豆芽孢杆菌;硝化细菌;地衣芽孢杆菌;植物乳杆菌;光合细菌;乳酸菌;肥水菌;底改活菌;EM菌种及培养基;等水产、畜禽养殖用微生态制剂单一菌粉;及复合菌粉及成品;益水素、亚硝净;特效水产酵母;破壁酵母;高活性饲料酵母;宠物风味酵母;发酵豆粕;生物有机肥发酵菌;等水产、畜禽用微生态制剂产品